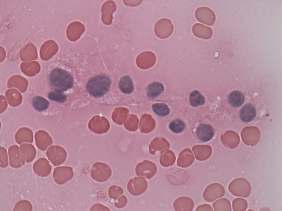

Study on 100 consecutive patients with thyroid nodule - case 004 |
|
Clinical presentation: A 47-year-old woman was referred for evaluation of a nodular goiter detected on ultrasound by chance. She was investigated because of complaints suggesting hypothyroidism.
Palpation: no abnormality.
Functional state: euthyroidism (TSH 2.38 mIU/L, aTPO < 3 U/mL).
Ultrasonography. The thyroid was echonormal and presented several discrete lesions, most had no significance. The only possible relevant lesion was a minimally-moderately hypoechogenic nodule in the lower third of the left lobe.
Cytology was performed form the nodule in the lower part of the left lobe and resulted in benign colloid goiter.
Suggestion: ultrasound in three years.